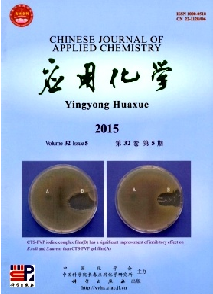
高校后勤研究

时间:2025-03-24 15:59 所属分类:科技期刊 点击次数:
应用化学核心期刊征稿,24小时热线:400-6800558,所属分类科技期刊,中国化学会;中国科学院单位主办,发行周期为月刊,栏目有 研究报告;文献综述;简报;专题研究应用化学欢迎投稿

应用化学简介
本刊1983年创刊,是经国家科委批准向国内外公开发行的学报类期刊,是由中国化学会、中国科学院长春应用化学研究所共同主办,中国科学院主管。应用化学期刊宗旨
本刊坚持为社会主义服务的方向,坚持以马克思列宁主义、毛泽东思想和邓小平理论为指导,贯彻“百花齐放、百家争鸣”和“古为今用、洋为中用”的方针,坚持实事求是、理论与实际相结合的严谨学风,传播先进的科学文化知识,弘扬民族优秀科学文化,促进国际科学文化交流与合作。应用化学栏目
研究报告;文献综述;简报;专题研究应用化学目录
线型二甲基硅氧烷低聚物的制备 曹都 夏勇 姚洪涛 祁争健 孙宇 李丰富
长链烷酸接枝羟丙基纤维素相变材料的制备及其性能 陈曦 郑楠 刘凌志 门永锋
新型取代胡椒醛缩合不对称卟啉金属配合物的微波合成及其抗菌活性 赵胜芳 陈年友 张寒梅 张京 李早英
α-羟基-α-氨甲酰基酰胺类化合物的合成新方法 陈晓娟 张文俊 陈建新
碱性金属修饰金属有机骨架材料MOF-5吸附位点及其常态下分离二氧化碳 CHAEMCHUEN Somboon 周奎 姚宸 罗志雄 VERPOORT Francis
4,4',6,6'-四叔丁基-2,2'-[乙二氧双(氮次甲基)]二酚 冯建华 吴刚
应用化学投稿须知
1.论文要求word电子文档,文稿格式要符合标准论文格式,文章内容要求原创、严禁抄袭。同一篇稿件切勿一稿多投,否则后果自负。
2.投稿请在论文后面注明作者简介(姓名,性别,籍贯,学历,职称,研究方向,从事的工作)工作单位、通讯地址、邮政编码、联系方式,方便网站工作人员及时与您沟通联系或快递期刊。通信地址格式如下:××省××市××县××路××号+单位名称,邮政编码,联系电话。
3.本站编辑部会及时处理所投稿件,一般审稿时间为3-4个工作日,核心期刊稿件为一周左右。
4. 本站编辑部根据期刊不同的版面要求,有权对稿件进行适当修改。
5. 本站为学术期刊咨询网,谢绝一切文学兴趣稿件的投递。
6. 稿件审核通过后传发采用通知,核实后付款。